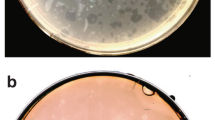

Abstract
Although the concept of programmed cell death (PCD) in bacteria has been met with scepticism, a growing body of evidence suggests that it can no longer be ignored. Several recent studies indicate that the phenotypic manifestations of apoptosis, which are processes that are associated with ordered cellular disassembly in eukaryotes, are conserved in bacteria. In this Opinion article, I propose a model for the coordinated control of potential bacterial PCD effectors and argue that the processes involved are functionally analogous to eukaryotic PCD systems.
This is a preview of subscription content, access via your institution
Access options
Subscribe to this journal
Receive 12 print issues and online access
$259.00 per year
only $21.58 per issue
Buy this article
- Purchase on SpringerLink
- Instant access to full article PDF
Prices may be subject to local taxes which are calculated during checkout


Similar content being viewed by others
References
Bayles, K. W. Are the molecular strategies that control apoptosis conserved in bacteria? Trends Microbiol. 11, 306–311 (2003).
Conover, M. S., Mishra, M. & Deora, R. Extracellular DNA is essential for maintaining Bordetella biofilm integrity on abiotic surfaces and in the upper respiratory tract of mice. PLoS ONE 6, e16861 (2011).
Harmsen, M., Lappann, M., Knochel, S. & Molin, S. Role of extracellular DNA during biofilm formation by Listeria monocytogenes. Appl. Environ. Microbiol. 76, 2271–2279 (2010).
Hu, W. et al. DNA builds and strengthens the extracellular matrix in Myxococcus xanthus biofilms by interacting with exopolysaccharides. PLoS ONE 7, e51905 (2012).
Lappann, M. et al. A dual role of extracellular DNA during biofilm formation of Neisseria meningitidis. Mol. Microbiol. 75, 1355–1371 (2010).
Martins, M. et al. Presence of extracellular DNA in the Candida albicans biofilm matrix and its contribution to biofilms. Mycopathologia 169, 323–331 (2010).
Rice, K. C. et al. The cidA murein hydrolase regulator contributes to DNA release and biofilm development in Staphylococcus aureus. Proc. Natl Acad. Sci. USA 104, 8113–8118 (2007).
Sahu, P. K., Iyer, P. S., Oak, A. M., Pardesi, K. R. & Chopade, B. A. Characterization of eDNA from the clinical strain Acinetobacter baumannii AIIMS 7 and its role in biofilm formation. Scientif. World J. 2012, 973436 (2012).
Thomas, V. C., Thurlow, L. R., Boyle, D. & Hancock, L. E. Regulation of autolysis-dependent extracellular DNA release by Enterococcus faecalis extracellular proteases influences biofilm development. J. Bacteriol. 190, 5690–5698 (2008).
Vilain, S., Pretorius, J. M., Theron, J. & Brozel, V. S. DNA as an adhesin: Bacillus cereus requires extracellular DNA to form biofilms. Appl. Environ. Microbiol. 75, 2861–2868 (2009).
Whitchurch, C. B., Tolker-Nielsen, T., Ragas, P. C. & Mattick, J. S. Extracellular DNA required for bacterial biofilm formation. Science 295, 1487 (2002).
Miura, M. Apoptotic and nonapoptotic caspase functions in animal development. Cold Spring Harb. Perspect. Biol. 4, a008664 (2012).
Boujrad, H., Gubkina, O., Robert, N., Krantic, S. & Susin, S. A. AIF-mediated programmed necrosis: a highly regulated way to die. Cell Cycle 6, 2612–2619 (2007).
Ouyang, L. et al. Programmed cell death pathways in cancer: a review of apoptosis, autophagy and programmed necrosis. Cell Prolif. 45, 487–498 (2012).
Kerr, J. F. R., Wylie, A. H. & Currie, A. R. Apoptosis: a basic biological phenomenon with wide-ranging implications in tissue kinetics. Br. J. Cancer 26, 239–257 (1972).
Thornberry, N. A. & Lazebnik, Y. Caspases: enemies within. Science 281, 1312–1316 (1998).
Kroemer, G., Galluzzi, L. & Brenner, C. Mitochondrial membrane permeabilization in cell death. Physiol. Rev. 87, 99–163 (2007).
Danial, N. N. & Korsmeyer, S. J. Cell death: critical control points. Cell 116, 205–219 (2004).
Rawlings, D. E. Proteic toxin-antitoxin, bacterial plasmid addiction systems and their evolution with special reference to the pas system of pTF-FC2. FEMS Microbiol. Lett. 176, 269–277 (1999).
Engelberg-Kulka, H., Amitai, S., Kolodkin-Gal, I. & Hazan, R. Bacterial programmed cell death and multicellular behavior in bacteria. PLoS Genet. 2, e135 (2006).
Zhang, Y. et al. MazF cleaves cellular mRNAs specifically at ACA to block protein synthesis in Escherichia coli. Mol. Cell 12, 913–923 (2003).
Amitai, S., Kolodkin-Gal, I., Hananya-Meltabashi, M., Sacher, A. & Engelberg-Kulka, H. Escherichia coli MazF leads to the simultaneous selective synthesis of both “death proteins” and “survival proteins”. PLoS Genet. 5, e1000390 (2009).
Pedersen, K., Christensen, S. K. & Gerdes, K. Rapid induction and reversal of a bacteriostatic condition by controlled expression of toxins and antitoxins. Mol. Microbiol. 45, 501–510 (2002).
Tait, S. W. & Green, D. R. Mitochondria and cell death: outer membrane permeabilization and beyond. Nature Rev. Mol. Cell Biol. 11, 621–632 (2010).
Walensky, L. D. & Gavathiotis, E. BAX unleashed: the biochemical transformation of an inactive cytosolic monomer into a toxic mitochondrial pore. Trends Biochem. Sci. 36, 642–652 (2011).
Bayles, K. W. The biological role of death and lysis in biofilm development. Nature Rev. Microbiol. 5, 721–726 (2007).
Bayles, K. W. The bactericidal action of penicillin: new clues to an unsolved mystery. Trends Microbiol. 8, 274–278 (2000).
Rice, K. C. & Bayles, K. W. Molecular control of bacterial death and lysis. Microbiol. Mol. Biol. Rev. 72, 85–109 (2008).
Groicher, K. H., Firek, B. A., Fujimoto, D. F. & Bayles, K. W. The Staphylococcus aureus lrgAB operon modulates murein hydrolase activity and penicillin tolerance. J. Bacteriol. 182, 1794–1801 (2000).
Rice, K. C. et al. The Staphylococcus aureus cidAB operon: evaluation of its role in regulation of murein hydrolase activity and penicillin tolerance. J. Bacteriol. 185, 2635–2643 (2003).
Ranjit, D. K., Endres, J. L. & Bayles, K. W. Staphylococcus aureus CidA and LrgA proteins exhibit holin-like properties. J. Bacteriol. 193, 2468–2476 (2011).
Pang, X. et al. Active Bax and Bak are functional holins. Genes Dev. 25, 2278–2290 (2011).
Dyall, S. D., Brown, M. T. & Johnson, P. J. Ancient invasions: from endosymbionts to organelles. Science 304, 253–257 (2004).
Embley, T. M. & Martin, W. Eukaryotic evolution, changes and challenges. Nature 440, 623–630 (2006).
Yang, Y. et al. A chloroplast envelope membrane protein containing a putative LrgB domain related to the control of bacterial death and lysis is required for chloroplast development in Arabidopsis thaliana. New Phytol. 193, 81–95 (2012).
Yamaguchi, M. et al. Loss of the plastid envelope protein AtLrgB causes spontaneous chlorotic cell death in Arabidopsis thaliana. Plant Cell Physiol. 53, 125–134 (2012).
Wang, J. & Bayles, K. W. Programmed cell death in plants: lessons from bacteria? Trends Plant Sci. 18, 133–139 (2013).
Ow, Y. P., Green, D. R., Hao, Z. & Mak, T. W. Cytochrome c: functions beyond respiration. Nature Rev. Mol. Cell Biol. 9, 532–542 (2008).
Li, P. et al. Cytochrome c and dATP-dependent formation of Apaf-1/caspase-9 complex initiates an apoptotic protease cascade. Cell 91, 479–489 (1997).
Aizenman, E., Engelberg-Kulka, H. & Glaser, G. An Escherichia coli chromosomal “addiction module” regulated by 3′,5′-bispyrophosphate: a model for programmed bacterial cell death. Proc. Natl Acad. Sci. USA 93, 6059–6063 (1996); erratum 93, 9991 (1996).
Jensen, R. B. & Gerdes, K. Programmed cell death in bacteria: proteic plasmid stabilization systems. Mol. Microbiol. 17, 205–210 (1995).
Naito, T., Kusano, K. & Kobayashi, I. Selfish behavior of restriction-modification systems. Science 267, 897–899 (1995).
Yarmolinsky, M. B. Programmed cell death in bacterial populations. Science 267, 836–837 (1995).
Gautam, S. & Sharma, A. Involvement of caspase-3-like protein in rapid cell death of Xanthomonas. Mol. Microbiol. 44, 393–401 (2002).
Gautam, S. & Sharma, A. Rapid cell death in Xanthomonas campestris pv. glycines. J. Gen. Appl. Microbiol. 48, 67–76 (2002).
Raju, K. K., Gautam, S. & Sharma, A. Molecules involved in the modulation of rapid cell death in Xanthomonas. J. Bacteriol. 188, 5408–5416 (2006).
Wadhawan, S., Gautam, S. & Sharma, A. Metabolic stress-induced programmed cell death in Xanthomonas. FEMS Microbiol. Lett. 312, 176–183 (2010).
Berman-Frank, I., Bidle, K. D., Haramaty, L. & Falkowsky, P. G. The demise of the marine cyanobacterium, Trichodesmium spp., via an autocatalyzed cell death pathway. Limnol. Oceanogr. 49, 997–1005 (2004).
Bidle, K. D. & Falkowski, P. G. Cell death in planktonic, photosynthetic microorganisms. Nature Rev. Microbiol. 2, 643–655 (2004).
Hakansson, A. P., Roche-Hakansson, H., Mossberg, A. K. & Svanborg, C. Apoptosis-like death in bacteria induced by HAMLET, a human milk lipid-protein complex. PLoS ONE 6, e17717 (2011).
Hakansson, A., Zhivotovsky, B., Orrenius, S., Sabharwal, H. & Svanborg, C. Apoptosis induced by a human milk protein. Proc. Natl Acad. Sci. USA 92, 8064–8068 (1995).
Svensson, M., Hakansson, A., Mossberg, A. K., Linse, S. & Svanborg, C. Conversion of α-lactalbumin to a protein inducing apoptosis. Proc. Natl Acad. Sci. USA 97, 4221–4226 (2000).
Dwyer, D. J., Camacho, D. M., Kohanski, M. A., Callura, J. M. & Collins, J. J. Antibiotic-induced bacterial cell death exhibits physiological and biochemical hallmarks of apoptosis. Mol. Cell 46, 561–572 (2012).
Bos, J., Yakhnina, A. A. & Gitai, Z. BapE DNA endonuclease induces an apoptotic-like response to DNA damage in Caulobacter. Proc. Natl Acad. Sci. USA 109, 18096–18101 (2012).
da Rocha, R. P., Paquola, A. C., Marques Mdo, V., Menck, C. F. & Galhardo, R. S. Characterization of the SOS regulon of Caulobacter crescentus. J. Bacteriol. 190, 1209–1218 (2008).
Erental, A., Sharon, I. & Engelberg-Kulka, H. Two programmed cell death systems in Escherichia coli: an apoptotic-like death is inhibited by the mazEF-mediated death pathway. PLoS Biol. 10, e1001281 (2012).
Amitai, S., Yassin, Y. & Engelberg-Kulka, H. MazF-mediated cell death in Escherichia coli: a point of no return. J. Bacteriol. 186, 8295–8300 (2004).
Vousden, K. H. Outcomes of p53 activation — spoilt for choice. J. Cell Sci. 119, 5015–5020 (2006).
Abedin, M. J., Wang, D., McDonnell, M. A., Lehmann, U. & Kelekar, A. Autophagy delays apoptotic death in breast cancer cells following DNA damage. Cell Death Differ. 14, 500–510 (2007).
Gozuacik, D. & Kimchi, A. Autophagy and cell death. Curr. Top. Dev. Biol. 78, 217–245 (2007).
Yu, L. et al. Regulation of an ATG7-beclin 1 program of autophagic cell death by caspase-8. Science 304, 1500–1502 (2004).
Vousden, K. H. & Prives, C. Blinded by the light: the growing complexity of p53. Cell 137, 413–431 (2009).
Millau, J. F., Bastien, N. & Drouin, R. p53 transcriptional activities: a general overview and some thoughts. Mutat. Res. 681, 118–133 (2009).
Sullivan, K. D., Gallant-Behm, C. L., Henry, R. E., Fraikin, J. L. & Espinosa, J. M. The p53 circuit board. Biochim. Biophys. Acta 1825, 229–244 (2012).
Garrett, J. M. & Young, R. Lethal action of bacteriophage λ S gene. J. Virol. 44, 886–892 (1982).
Moreillon, P., Markiewicz, Z., Nachman, S. & Tomasz, A. Two bactericidal targets for penicillin in pneumococci: autolysis-dependent and autolysis-independent killing mechanisms. Antimicrob. Agents Chemother. 34, 33–39 (1990).
Kroemer, G. & Levine, B. Autophagic cell death: the story of a misnomer. Nature Rev. Mol. Cell Biol. 9, 1004–1010 (2008).
Rodriguez-Rocha, H., Garcia-Garcia, A., Panayiotidis, M. I. & Franco, R. DNA damage and autophagy. Mutat. Res. 711, 158–166 (2011).
Ryan, K. M. p53 and autophagy in cancer: guardian of the genome meets guardian of the proteome. Eur. J. Cancer 47, 44–50 (2011).
Enari, M. et al. A caspase-activated DNase that degrades DNA during apoptosis, and its inhibitor ICAD. Nature 391, 43–50 (1998).
Liu, X., Zou, H., Slaughter, C. & Wang, X. DFF, a heterodimeric protein that functions downstream of caspase-3 to trigger DNA fragmentation during apoptosis. Cell 89, 175–184 (1997).
Wyllie, A. H. Glucocorticoid-induced thymocyte apoptosis is associated with endogenous endonuclease activation. Nature 284, 555–556 (1980).
Gavrieli, Y., Sherman, Y. & Ben-Sasson, S. A. Identification of programmed cell death in situ via specific labeling of nuclear DNA fragmentation. J. Cell Biol. 119, 493–501 (1992).
Op den Kamp, J. A. F. Lipid asymmetry in membranes. Ann. Rev. Biochem. 48, 47–71 (1979).
Fadok, V. A. et al. Exposure of phosphatidylserine on the surface of apoptotic lymphocytes triggers specific recognition and removal by macrophages. J. Immunol. 148, 2207–2216 (1992).
Koopman, G. et al. Annexin V for flow cytometric detection of phosphatidylserine expression on B cells undergoing apoptosis. Blood 84, 1415–1420 (1994).
Acknowledgements
The author would like to thank X. Luo for lending his expertise on apoptosis, and K. Nelson for her editorial assistance in the development of this manuscript. Work conducted in the author's laboratory is supported by grants from the US National Institutes of Health (P01-AI83211 and R01-AI038901).
Author information
Authors and Affiliations
Corresponding author
Ethics declarations
Competing interests
The author declares no competing financial interests.
PowerPoint slides
Rights and permissions
About this article
Cite this article
Bayles, K. Bacterial programmed cell death: making sense of a paradox. Nat Rev Microbiol 12, 63–69 (2014). https://doi.org/10.1038/nrmicro3136
Published:
Issue date:
DOI: https://doi.org/10.1038/nrmicro3136
This article is cited by
-
Mortality by ribosomal sequencing (MoRS) provides a window into taxon-specific cell lysis
The ISME Journal (2023)
-
Formation of necromass-derived soil organic carbon determined by microbial death pathways
Nature Geoscience (2023)
-
The concepts and origins of cell mortality
History and Philosophy of the Life Sciences (2023)
-
Response of cytotoxin production ability to gene expression and cell molecular structure of Microcystis aeruginosa FACHB-905
Environmental Science and Pollution Research (2023)
-
Transcriptomics analysis provides insights into the heat adaptation strategies of an Antarctic bacterium, Cryobacterium sp. SO1
Polar Biology (2023)